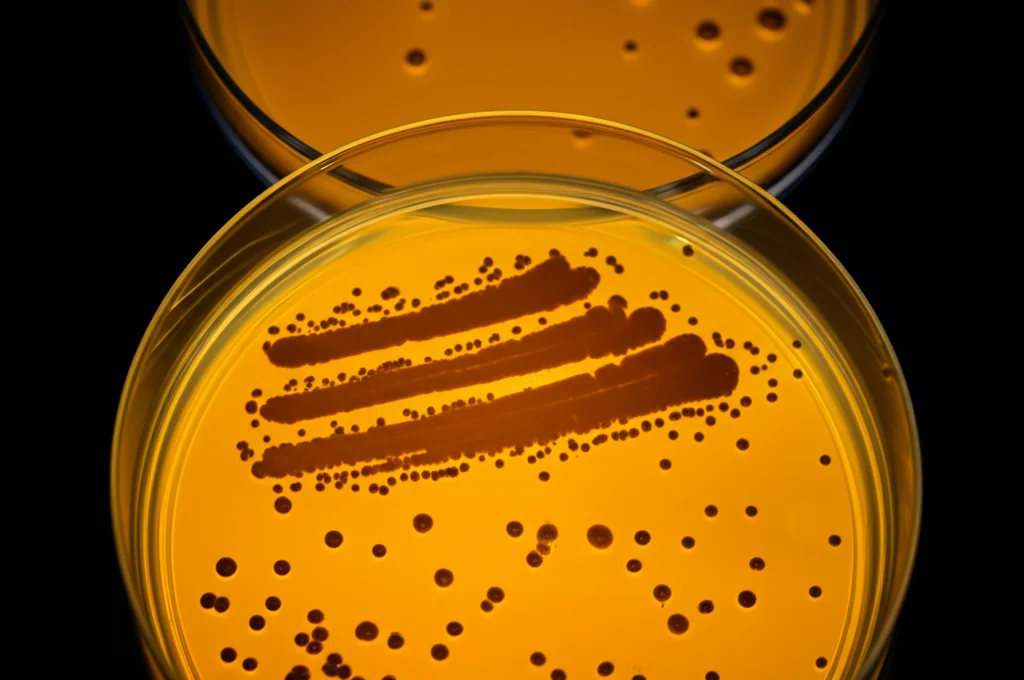
Fotografia macro, obiettivo 90mm, piastra di Petri che mostra colonie batteriche di Burkholderia gladioli sotto illuminazione controllata da laboratorio, alto dettaglio, messa a fuoco precisa.

Batterio Killer nel Gel Ecografico: Un’Indagine Shock Rivela Rischi Nascosti
Ciao a tutti! Oggi voglio parlarvi di qualcosa che forse diamo un po’ troppo per scontato: la sicurezza di procedure mediche comunissime come le ecografie. Avete mai pensato a cosa c’è dentro quel gel trasparente che spalmano sulla pelle prima di passare la sonda? Beh, preparatevi, perché quello che sto per raccontarvi ha dell’incredibile e ci riguarda tutti da vicino.
Un Batterio Inatteso
Immaginate la scena: siamo in un grande ospedale generale, nel reparto di ecografia interventistica. Luglio 2023. Da un campione di liquido ascitico di un paziente, prelevato dopo un intervento guidato da ultrasuoni per metastasi epatiche da cancro al pancreas, salta fuori un ospite indesiderato e piuttosto raro: il Burkholderia gladioli. Ora, magari questo nome non vi dice molto, ma fidatevi, è un batterio Gram-negativo che di solito se ne sta tranquillo nell’acqua, nel suolo, sulle piante. Non è il tipo che ci si aspetta di trovare in un ambiente ospedaliero, tanto che in quell’ospedale non si vedeva da almeno tre anni! Questo campanello d’allarme ha fatto scattare subito un’indagine epidemiologica. Il paziente, dopo l’intervento, ha avuto un po’ di febbre, ma nessun segno chiaro di infezione grave, ed è stato dimesso dopo cinque giorni. Ma la domanda rimaneva: da dove diavolo era saltato fuori quel batterio?
Caccia al Colpevole
Quando succede qualcosa del genere, la prima cosa da fare è mettersi i guanti da detective e iniziare a cercare la fonte. L’ipotesi più probabile era che la contaminazione fosse avvenuta durante la procedura chirurgica. Così, abbiamo iniziato a passare al setaccio tutto l’ambiente della sala operatoria del reparto di ecografia interventistica. Campioni dall’aria, dagli strumenti chirurgici, dall’acqua utilizzata, dalle soluzioni sterili, dalle mani del personale medico… persino dalla sonda ecografica stessa. E poi, ovviamente, lui: il gel ecografico, o “agente di accoppiamento ultrasonico”, come lo chiamano i tecnici. Abbiamo prelevato campioni sia da flaconi già aperti e in uso, sia da flaconi nuovi, ancora sigillati, di diverse marche e lotti. Sia gel sterili che non sterili. L’obiettivo era capire se il batterio si nascondesse lì. Abbiamo seguito protocolli rigorosi per la raccolta e l’analisi, coltivando i campioni per vedere cosa cresceva.
Il Gel Sotto Accusa
E bingo! Mentre aria, acqua, strumenti e mani del personale erano puliti, il Burkholderia gladioli è stato isolato proprio nel gel ecografico non sterile, sia quello in uso che quello ancora sigillato! Ma la prova del nove doveva ancora arrivare. Abbiamo confrontato il DNA del batterio isolato dal paziente con quello trovato nel gel. Utilizzando una tecnica chiamata ANI (Average Nucleotide Identity), che misura la somiglianza genetica, abbiamo scoperto che i due ceppi erano identici al 100%. Stesso clone. Non c’erano più dubbi: la fonte della contaminazione era proprio quel gel. Abbiamo anche testato la sensibilità agli antibiotici: entrambi i ceppi (quello del paziente e quello del gel) mostravano esattamente lo stesso profilo di resistenza e sensibilità. Resistenti ad aztreonam e colistina, moderatamente sensibili a cefalosporine di terza e quarta generazione, e sensibili a molti altri antibiotici comuni.
All’Origine della Contaminazione
Ma come ci era finito il batterio nel gel, addirittura in flaconi nuovi? Abbiamo contattato il produttore del gel. È venuto fuori che il serbatoio di stoccaggio dell’acqua utilizzata nella linea di produzione non veniva pulito e disinfettato da anni! Una negligenza incredibile che ha permesso al batterio di proliferare e contaminare il prodotto finito. Una volta pulita e disinfettata la linea dell’acqua, i lotti successivi di gel sono risultati conformi agli standard. Un sospiro di sollievo, ma anche un monito importante sulla filiera produttiva.
Non Solo un Caso Isolato: I Rischi Diffusi
Questa scoperta ci ha spinto ad allargare l’indagine a tutto l’ospedale, campionando diversi gel e sonde ecografiche in uso tra agosto e dicembre 2023. I risultati sono stati, francamente, preoccupanti:
- Il tasso di conformità (cioè il numero di batteri entro i limiti di sicurezza) del gel non sterile era bassissimo: solo il 18,37% dei campioni era a posto! E questo valeva per diverse marche.
- Al contrario, il gel sterile era conforme al 100%.
- Nel gel non sterile di una delle marche sono stati trovati anche altri batteri potenzialmente pericolosi, come quelli del complesso Burkholderia cepacia.
Ma non è finita qui. Abbiamo controllato anche le sonde ecografiche dopo l’uso. Ebbene, anche quando si usava un gel “conforme” (cioè con carica batterica bassa), la sonda risultava contaminata oltre i limiti nel 56% dei casi. Se poi si usava il gel contaminato, questa percentuale saliva all’88%! Questo ci dice che la semplice pulizia superficiale spesso non basta.
Disinfezione: Cosa Funziona Davvero?
La buona notizia è che una disinfezione fatta bene funziona. Abbiamo confrontato diversi metodi:
- Le sonde a medio e alto rischio disinfettate con luce ultravioletta (UV) erano conformi al 100% (sterili, nessuna crescita batterica).
- Le sonde disinfettate con salviette disinfettanti specifiche avevano un tasso di conformità del 90%.
La differenza tra le sonde appena usate (altamente contaminate) e quelle disinfettate era statisticamente enorme (P < 0.001). Morale della favola: la disinfezione accurata dopo ogni singolo utilizzo ("one disinfection after use by one person") è assolutamente cruciale. Eppure, sappiamo che per motivi di tempo o economici, questo spesso non viene fatto rigorosamente, specialmente per le sonde a basso rischio. A volte vengono solo pulite con salviette di carta!

Il Pericolo Nascosto sulle Macchine Ecografiche Mobili
Un altro aspetto spesso trascurato è la contaminazione delle macchine ecografiche stesse, specialmente quelle portatili usate al letto del paziente. Abbiamo campionato le superfici ad alto contatto (sonda, pannello, maniglia, superficie dello strumento) e le mani degli operatori. Risultato? Nel 13,04% dei casi abbiamo trovato batteri multi-resistenti agli antibiotici, i cosiddetti “superbatteri”: 4 ceppi di Acinetobacter baumannii resistente ai carbapenemi (CRAB) e 2 ceppi di Klebsiella pneumoniae resistente ai carbapenemi (CRKP). Questi batteri si trasmettono per contatto e le apparecchiature condivise come gli ecografi possono diventare veicoli di infezione, un rischio spesso sottovalutato nella gestione delle infezioni ospedaliere.
Cosa Possiamo Fare? Lezioni Apprese
Questo caso ci ha insegnato molto. L’ospedale ha immediatamente ritirato e smesso di usare la marca di gel contaminata. Ma le azioni correttive devono essere più ampie:
- Usare gel sterile: È fondamentale per tutte le procedure a medio e alto rischio (come ecografie transesofagee, vaginali, interventistiche) e per le valutazioni pre-operatorie.
- Standardizzare la disinfezione delle sonde: Il principio “una disinfezione dopo ogni uso per ogni paziente” deve diventare la regola, non l’eccezione, usando metodi efficaci come salviette disinfettanti o UV.
- Monitoraggio e controllo qualità: Gli ospedali devono scegliere fornitori affidabili e testare periodicamente i gel. Le agenzie regolatorie devono vigilare sui produttori.
- Formazione del personale: Medici e infermieri devono essere consapevoli di questi rischi, saper riconoscere infezioni anomale e applicare correttamente le procedure di controllo delle infezioni. L’igiene delle mani e la disinfezione delle apparecchiature sono fondamentali.
- Sistemi di sorveglianza: I sistemi informativi ospedalieri sono preziosi per identificare precocemente batteri rari o pattern insoliti che possono indicare un focolaio.
Dopo l’implementazione di queste misure, fortunatamente, non sono stati rilevati altri casi di B. gladioli né nel paziente originale (che ha continuato le sue cure) né in altri pazienti ricoverati.
Occhi Aperti!
Questa storia ci ricorda che la sicurezza in ambito sanitario dipende da tanti fattori, anche quelli che sembrano più banali come un gel per ecografie. Non dobbiamo mai abbassare la guardia. La vigilanza costante, l’applicazione rigorosa dei protocolli, la formazione continua e un pizzico di “fiuto” investigativo quando qualcosa non torna, sono essenziali per prevenire le infezioni ospedaliere e proteggere la salute di tutti noi. La prossima volta che farete un’ecografia, magari penserete a questa storia, non per spaventarvi, ma per apprezzare l’importanza delle procedure di sicurezza che (si spera!) vengono messe in atto.
Fonte: Springer







